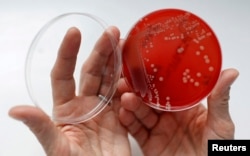
FILE- An employee displays MRSA (Methicillin-resistant Staphylococcus aureus) bacteria strain inside a petri dish containing agar jelly for bacterial culture in a microbiological laboratory in Berlin.

An international team of scientists has identified a new strain of “superbug” that has made people sick, and it apparently came from chickens.
The new strain of Methicillin-resistant Staphylococcus aureus, better known as MRSA, sickened 10 people in Denmark. Researchers traced the staph bacteria, which is resistant to several antibiotics, and can be fatal, to contaminated poultry people handled or ate.
Most people don’t acquire MRSA from chickens or other food animals. It’s usually spread in hospitals, through person-to-person contact, where people live and gather in close quarters in the community. While farm workers are at higher risk of becoming ill with staph infections, the new strain was acquired by city dwellers.
The latest findings, published in the journal Clinical Infectious Diseases, demonstrate that MRSA, which is known to exist in pork, beef and dairy products, can be spread to people through contact with infected animal products.
In the study, researchers used genetic analysis to compare the strains of MRSA found in the 10 Danes to staph infection in other people and in livestock. The analysis showed it was exactly the same MRSA strain found in contaminated poultry. The chicken meat was imported from other countries, including France, the Netherlands and Germany.
Last week, the United Nations hosted a high level meeting of hundreds of experts on antibiotic resistance to discuss how it will become a global crisis if nothing is done.
The participants called for a number of collaborative measures by public and private sectors to ensure the smart use of antibiotics.
One of those in attendance was Laura MacCleery, Vice President for Consumer Policy and Mobilization at Consumers Union based in Washington D.C.
One of the group’s main concerns is the overuse and misuse of antibiotics in livestock, which can make the drugs ineffective and create superbugs like MRSA.
“Animals are routinely given sub-therapeutic doses of antibiotics because the conditions in which they live are unsanitary,” said MacCleery.
While the drugs are designed to keep the food animals healthy and promote their growth, the antibiotics, and the bacteria resistant to them, can be passed along the food chain to humans.
At the U.N. meeting, MacCleery said a number of measures were discussed to reduce antibiotic resistance, not only in animals as a source, but in general.
“Drug pricing and availability at a level of provider incentives, those are the kinds of things that governments can do to discourage inappropriate prescribing among physicians, and to educate consumers about the potential risk of antibiotic resistance,” said MacCleery.
MacCleery said Consumers Union has been successful in getting a number of fast food chains, including MacDonald’s, to commit to not using chicken that has been treated with antibiotics.
Meanwhile, researchers predict there will be a rise in new, more virulent strains of MRSA if antibiotics continue to be used in livestock.